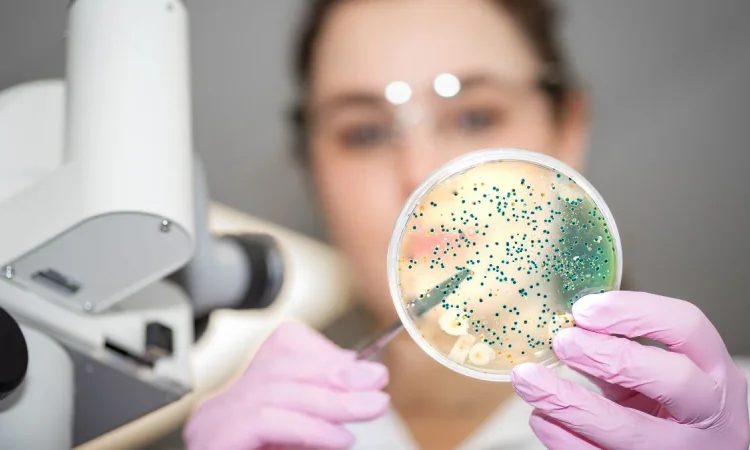

Microbiome health is characterized by increased microbial diversity and abundance as well as greater phenotypic versatility. Physical activity & microbiota composition have bidirectional effects. With regular physical activity, improving microbial composition enhances physical performance. This is proved by multiple studies, hence it cannot be denied that this relationship between exercise and gut microbiome is the real influence. It can provide a useful route to influence athletic performance via microbiome manipulation.
Understanding Microbiome Health in Young Athletes
The term "microbiome" refers to the trillions of bacteria, fungi, and other microorganisms that reside in the digestive tract. While the gut microbiome has been studied for its role in digestion and immunity, newer research points to its influence on inflammation control, nutrient absorption, recovery times, and even mental focus—all critical factors for developing athletes.
Microbiome health becomes especially important during childhood and adolescence, when bodies are still developing, and physical demands are increasing through sports participation. A well-balanced gut microbiome can serve as a natural performance enhancer, fortifying young athletes from the inside out.
The Link Between Gut and Game

Emerging data from institutions like the American Gut Project suggest that active individuals tend to have more diverse gut microbiomes than sedentary ones. This diversity correlates with better metabolic health and reduced inflammation—two metrics crucial for high-performance sports.
In a study published in the journal Gut Microbes, researchers found that exercise increased microbial diversity and improved short-chain fatty acid production, which is essential for maintaining gut lining integrity and supporting energy metabolism. These are not just clinical findings but practical implications for coaches, sports organizations, and even policymakers.
Why C-Suite Leaders Should Pay Attention
From athletic apparel companies to youth training academies and nutrition startups, there is a growing market around functional performance. For C-suite executives and startup founders, microbiome health represents both a wellness imperative and a commercial opportunity.
Companies like Thorne, Seed, and Viome are developing microbiome-driven products aimed at improving athletic output. Investors and business leaders in the fitness, health tech, and sports nutrition industries can no longer afford to ignore the strategic significance of gut health in youth athletics.
Nutrition: The Cornerstone of Microbiome Health

One of the most straightforward ways to influence microbiome health is through diet. Foods rich in fiber, fermented products like yogurt and kefir, and prebiotic ingredients found in fruits and vegetables help feed beneficial bacteria. Unfortunately, many young athletes in the U.S. still consume highly processed diets that can disturb gut balance.
A survey conducted by the CDC revealed that only 9% of U.S. high school students eat the recommended amount of vegetables, and just 7% meet fruit intake guidelines. This dietary gap poses not only a public health issue but also a performance barrier for aspiring athletes.
Probiotics and Supplementation
Probiotic supplementation is increasingly common among youth athletes, especially those in elite or travel teams where recovery time is limited. While more research is needed on dosage and strain specificity, preliminary data shows promise. A 2020 meta-analysis in the Journal of the International Society of Sports Nutrition noted modest but statistically significant performance gains and reduced incidence of gastrointestinal distress among athletes taking targeted probiotics.
For startup founders and R&D departments in the supplement industry, this points to an expanding niche within sports-specific probiotic products aimed at optimizing microbiome health in younger populations.
Microbiome Testing: The Next Frontier
Personalized training and nutrition regimens are on the rise, and microbiome testing is playing a central role. Companies are offering at-home test kits that analyze gut health to deliver tailored dietary recommendations. Youth training programs are beginning to integrate these insights to improve everything from energy levels to focus and stamina.
For MNC managers, particularly in health tech and diagnostics, incorporating microbiome analytics into product portfolios can provide a competitive edge. It aligns with the rising demand for precision health solutions and enhances brand value in a health-conscious market.
Mental Toughness Starts in the Gut
The gut-brain axis, a bidirectional communication system between the gastrointestinal tract and the central nervous system, highlights another compelling angle of microbiome health. Anxiety, stress management, and even decision-making—all key to athletic success—can be influenced by the state of the gut.
According to the National Institute of Mental Health, nearly one in three adolescents in the U.S. struggles with an anxiety disorder. Incorporating gut-friendly practices into youth athletic training may offer a novel way to support mental resilience, a feature now recognized as equally vital as physical skill in sports.
Schools and Sports Programs: A Call to Action
Given the compelling evidence, it's time for U.S. schools and youth sports organizations to make microbiome health a standard part of athletic training and education. From updating cafeteria menus to integrating gut education into health classes, there are numerous low-cost, high-impact strategies available.
Corporate social responsibility initiatives can also play a role. Brands targeting youth sports can partner with educational institutions to promote gut-friendly habits through sponsorships, toolkits, and awareness campaigns. These collaborations can boost brand equity while contributing positively to public health.
Conclusion
As the science matures, one thing becomes clear: fostering microbiome health isn’t a luxury; it’s a necessity for the next generation of athletes. In a landscape where marginal gains make the difference between podium finishes and missed opportunities, gut health offers a hidden yet potent lever.
For C-suite leaders, investors, and managers, now is the time to act. Whether through product development, partnerships, or community engagement, the gut is becoming the gateway to future athletic and commercial success. By building resilient bodies from the inside out, we also build a stronger, more innovative business ecosystem around youth sports in the U.S.
Leave a Reply
Your email address will not be published.